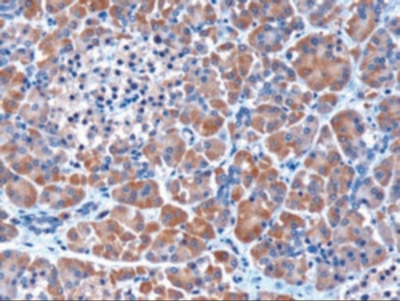

MEPI ANTIBODY ,Each
$ 1,020.14
|
|
Details:
MEPI Antibody^ Polyclonal antibody MEPI Host: Goat Target Species: human immunogen: MEPI antibody was raised against a 14 amino acid synthetic peptide near the internal region of MEPI Application: ELISA, WB, IHC
Additional Information
| SKU | 23468331 |
|---|---|
| UOM | EACH |
| UNSPSC | 12352203 |
| Manufacturer Part Number | 45-884 |
| Product Dimensions | 1X1X1 Inches |
| Product Weight | 0.1 |

